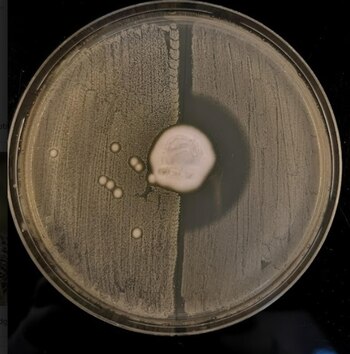

Redacción ciencia, 5 ene (EFE).- El descubrimiento de los antibióticos hace más de 80 años supuso un antes y un después en la salud humana y animal, pero tras décadas de abuso y mal uso de estos fármacos, muchos patógenos humanos se han hecho resistentes a los antibióticos.
La resistencia a los antibióticos es uno de los mayores problemas de salud global, y saber cómo se producen es esencial para combatir este fenómeno creciente.
Para averiguar más, un equipo internacional liderado por la Universidad de Cambridge, el Instituto Wellcome Sanger, el Serum Statens Institut de Dinamarca, y el Real Jardín Botánico de Kew, y en el que han participado microbiólogos de Lugo y Salamanca, ha rastreado la historia genética de la bacteria Staphylococcus aureus.
El estudio, publicado hoy en Nature, concluye que esta bacteria desarrolló por primera vez resistencia a la meticilina de manera natural, hace unos dos siglos.
Los investigadores creen que la resistencia a los antibióticos evolucionó en el Staphylococcus aureus como adaptación al tener que convivir en la piel de los erizos con el hongo Trichophyton erinacei, que produce sus propios antibióticos.
Como resultado de esta convivencia, el Staphylococcus aureus se hizo resistente a la meticilina y dio lugar a la superbacteria SARM, que surgió de manera natural cientos de años antes de que los antibióticos de uso médico y agrícola empezasen a perder efectividad.
"Gracias a la tecnología de secuenciación, hemos rastreado los genes que confieren al mecC-MRSA su resistencia a los antibióticos hasta su primera aparición, y hemos descubierto que ya existían en el siglo XIX", explica Ewan Harrison, investigador del Instituto Wellcome Sanger y de la Universidad de Cambridge.
"Nuestro estudio sugiere que no fue el uso de la penicilina lo que impulsó la aparición inicial del SARM, sino que fue un proceso biológico natural. Creemos que el SARM evolucionó en una batalla por la supervivencia en la piel de los erizos, y después se extendió al ganado y a los humanos con el contacto directo", detalla.
Hasta ahora se pensaba que la resistencia a los antibióticos era un fenómeno moderno impulsado por el uso clínico de estos fármacos pero el estudio constata que, si bien el mal uso de los antibióticos ha acelerado el proceso, el fenómeno natural comenzó mucho antes.
El estudio advierte de que el uso excesivo de cualquier antibiótico en los seres humanos o el ganado favorece la aparición de cepas resistentes del bicho, por lo que es solo 'cuestión de tiempo' que el antibiótico pierda su eficacia.
"Este estudio es una cruda advertencia de que cuando usamos antibióticos, tenemos que hacerlo con cuidado. Hay un gran 'reservorio' en la fauna silvestre donde pueden sobrevivir las bacterias resistentes a los antibióticos, y de ahí a que sean recogidas por el ganado y luego infecten a los humanos hay un paso muy corto", afirma Mark Holmes, de la Universidad de Cambridge y autor principal del estudio.
En 2011, una investigación de Holmes identificó por primera vez el mecC-MRSA en poblaciones humanas y vacas lecheras. Entonces se asumió que la cepa había surgido en las vacas por la gran cantidad de antibióticos que se les administra de forma rutinaria.
El SARM se identificó por primera vez en pacientes en 1960, y alrededor de 1 de cada 200 de todas las infecciones por SARM están causadas por el mecC-MRSA.
Por su resistencia a los antibióticos, el SARM es mucho más difícil de tratar que otras infecciones bacterianas y la Organización Mundial de la Salud lo considera una de las mayores amenazas para la salud humana y un importante reto en la ganadería.
El estudio subraya que estos hallazgos no son una razón para temer a los erizos, porque los seres humanos rara vez se infectan con el SARM-MecC, a pesar de que ha estado presente en los erizos durante más de 200 años.
Pero "no solo los erizos albergan bacterias resistentes a los antibióticos: toda la fauna silvestre es portadora de muchos tipos diferentes de bacterias, así como de parásitos, hongos y virus", advierte Holmes.
"Los animales salvajes, el ganado y los seres humanos están interconectados: todos compartimos un ecosistema. No es posible entender la evolución de la resistencia a los antibióticos si no se observa el sistema en su conjunto".
Últimas Noticias
Condenados en Alemania a penas de hasta seis años de prisión cuatro personas acusadas de pertenecer a Hamás

El Senado de EEUU rechaza una nueva moción para detener la ofensiva contra Irán
Donald Trump mantiene la autoridad para emplear fuerzas armadas en Oriente Próximo tras fracasar en el Congreso una iniciativa demócrata destinada a limitar su capacidad de acción, pese a las fracturas internas y la presión internacional creciente

Aagesen destaca cooperación con iberoamérica para avanzar en transición ecológica, clave para "una sociedad más justa"

Lagarde asegura que el BCE no titubeará en su respuesta a la crisis de Irán
La presidenta del organismo europeo advirtió que, aunque no tomarán medidas inmediatas frente a las tensiones en Oriente Próximo, su equipo evaluará cuidadosamente los riesgos y reaccionará de manera decidida para garantizar la estabilidad de precios y cumplir sus objetivos inflacionarios

Madring completará el asfaltado de la parcela de Valdebebas durante "esta semana y la próxima"
Los trabajos en Valdebebas avanzan con agilidad, según anunció la organización del circuito, que prevé finalizar el recubrimiento del trazado en los próximos días, mientras la edificación de los garajes mantiene el ritmo planificado de cara al evento de septiembre
